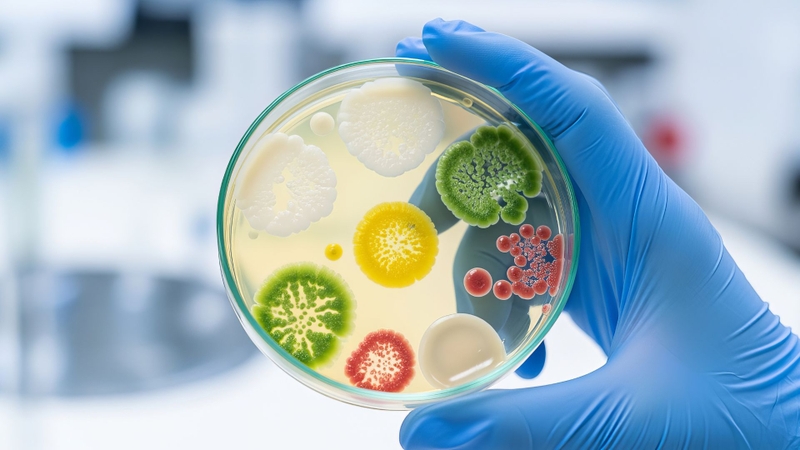
Benzoic Acid chủ yếu ức chế sự phát triển của vi khuẩn, nấm men và nấm mốc

- Tìm hiểu chung
- Liều dùng & cách dùng
- Ứng dụng
- Lưu ý
- Tìm hiểu chung
- Liều dùng & cách dùng
- Ứng dụng
- Lưu ý
Benzoic Acid là gì? Tác dụng và ứng dụng
02/04/2026
Mặc định
Lớn hơn
Benzoic Acid là một hợp chất hữu cơ thuộc nhóm acid carboxylic, thường được sử dụng làm chất bảo quản trong thực phẩm, mỹ phẩm và dược phẩm. Hoạt chất này có khả năng ức chế sự phát triển của vi khuẩn, nấm men và nấm mốc, giúp kéo dài thời gian bảo quản sản phẩm. Trong y học, Benzoic Acid còn được dùng trong một số chế phẩm bôi ngoài da để hỗ trợ điều trị một số nhiễm nấm ngoài da. Tuy nhiên, việc sử dụng cần tuân thủ liều lượng quy định để đảm bảo an toàn.
- Tìm hiểu chung
- Liều dùng & cách dùng
- Ứng dụng
- Lưu ý
- Tìm hiểu chung
- Liều dùng & cách dùng
- Ứng dụng
- Lưu ý
Tìm hiểu chung
Benzoic Acid là gì?
Benzoic Acid là một hợp chất hữu cơ thuộc nhóm acid carboxylic thơm, có công thức hóa học C₆H₅COOH. Đây là một trong những acid thơm đơn giản nhất, được cấu tạo từ một vòng benzen liên kết với nhóm carboxyl (-COOH). Trong điều kiện bình thường, Benzoic Acid tồn tại ở dạng tinh thể rắn màu trắng, ít tan trong nước nhưng tan tốt hơn trong dung môi hữu cơ như ethanol hoặc ether.
Trong tự nhiên, Benzoic Acid có thể được tìm thấy với lượng nhỏ trong một số loại thực vật và thực phẩm như quả mọng, mận, quế hoặc đinh hương. Tuy nhiên, phần lớn Benzoic Acid được sản xuất bằng phương pháp tổng hợp trong công nghiệp để phục vụ cho nhiều lĩnh vực khác nhau.
Một trong những đặc tính quan trọng của Benzoic Acid là khả năng ức chế sự phát triển của vi sinh vật, đặc biệt là vi khuẩn, nấm men và nấm mốc. Nhờ đặc điểm này, hợp chất được sử dụng rộng rãi như một chất bảo quản nhằm kéo dài thời gian sử dụng của thực phẩm và đồ uống. Trong công nghiệp thực phẩm, Benzoic Acid và các muối của nó (như natri benzoat) thường được thêm vào các sản phẩm có tính acid như nước giải khát, nước trái cây hoặc nước chấm để hạn chế sự phát triển của vi sinh vật.
Ngoài lĩnh vực thực phẩm, Benzoic Acid còn được ứng dụng trong nhiều ngành khác. Trong dược phẩm, hoạt chất này có thể được dùng trong một số chế phẩm bôi ngoài da để hỗ trợ điều trị nhiễm nấm hoặc nhiễm khuẩn nhẹ trên da. Trong công nghiệp hóa chất, Benzoic Acid cũng là nguyên liệu trung gian quan trọng để tổng hợp nhiều hợp chất hữu cơ khác, bao gồm chất bảo quản, hương liệu, nhựa và thuốc nhuộm.

Điều chế sản xuất Benzoic Acid
Benzoic Acid có thể được tạo ra từ nhiều phương pháp khác nhau, bao gồm cả nguồn tự nhiên và quá trình tổng hợp trong công nghiệp. Tuy nhiên, trong thực tế sản xuất quy mô lớn, phương pháp tổng hợp hóa học được sử dụng phổ biến hơn vì cho hiệu suất cao và dễ kiểm soát chất lượng.
Trong tự nhiên, Benzoic Acid có thể được hình thành từ quá trình chuyển hóa của một số hợp chất thơm trong thực vật, đặc biệt từ các tiền chất như benzaldehyde hoặc phenylalanine. Chất này có thể được tìm thấy với lượng nhỏ trong nhiều loại quả như nam việt quất, mận hoặc một số loại gia vị như quế và đinh hương. Tuy nhiên, hàm lượng tự nhiên khá thấp nên không phù hợp để khai thác làm nguồn nguyên liệu chính cho công nghiệp.
Trong công nghiệp hóa chất, phương pháp sản xuất Benzoic Acid phổ biến nhất là oxy hóa toluen bằng oxy trong không khí. Quá trình này thường được thực hiện trong điều kiện nhiệt độ khoảng 150 - 200 °C và áp suất cao, có sự tham gia của các chất xúc tác như muối coban hoặc mangan. Trong phản ứng này, nhóm methyl (-CH₃) của toluen bị oxy hóa dần thành nhóm carboxyl (-COOH), từ đó tạo ra Benzoic Acid. Phương pháp này có ưu điểm là nguồn nguyên liệu toluen dễ kiếm, chi phí thấp và hiệu suất phản ứng cao nên được sử dụng rộng rãi trong sản xuất công nghiệp.
Ngoài ra, trong phòng thí nghiệm hoặc quy mô nhỏ, Benzoic Acid cũng có thể được điều chế bằng cách oxy hóa các hợp chất thơm có mạch nhánh, chẳng hạn như benzyl alcohol hoặc benzaldehyde, bằng các chất oxy hóa mạnh như kali permanganat (KMnO₄) hoặc kali dicromat (K₂Cr₂O₇). Phản ứng oxy hóa sẽ chuyển nhóm chức trên mạch nhánh thành nhóm carboxyl, tạo ra Benzoic Acid.
Cơ chế hoạt động
Benzoic Acid hoạt động chủ yếu dựa trên khả năng ức chế sự phát triển của vi sinh vật, đặc biệt là vi khuẩn, nấm men và nấm mốc. Tác dụng này liên quan trực tiếp đến tính chất acid yếu của hợp chất và khả năng ảnh hưởng đến môi trường bên trong tế bào vi sinh vật.
Trong môi trường có pH acid, Benzoic Acid tồn tại phần lớn ở dạng không phân ly (dạng phân tử tự do). Ở trạng thái này, phân tử có thể dễ dàng khuếch tán qua màng tế bào của vi sinh vật. Khi đi vào bên trong tế bào, Benzoic Acid sẽ phân ly thành ion benzoat và ion hydro (H⁺).
Sự phân ly này gây ra một số tác động sinh học quan trọng:
- Làm giảm pH nội bào, khiến môi trường bên trong tế bào trở nên acid hơn, từ đó ảnh hưởng đến hoạt động của nhiều enzyme thiết yếu.
- Rối loạn quá trình trao đổi chất của vi sinh vật, đặc biệt là các phản ứng liên quan đến hô hấp tế bào và chuyển hóa năng lượng.
- Ức chế hoạt động của enzyme, từ đó làm gián đoạn quá trình tổng hợp các thành phần cần thiết cho sự sinh trưởng của vi sinh vật.
Kết quả là vi sinh vật bị kìm hãm sự phát triển hoặc không thể sinh trưởng, nhờ đó Benzoic Acid phát huy tác dụng bảo quản thực phẩm và hạn chế sự hư hỏng do vi sinh vật gây ra. Hiệu quả của cơ chế này thường tăng lên trong môi trường có pH thấp, vì khi đó tỷ lệ Benzoic Acid ở dạng không phân ly cao hơn, giúp chất dễ xâm nhập vào tế bào vi sinh vật.
Công dụng
Benzoic Acid được biết đến chủ yếu nhờ khả năng ức chế sự phát triển của nhiều loại vi sinh vật như vi khuẩn, nấm men và nấm mốc. Nhờ đặc tính này, hợp chất thường được sử dụng với vai trò bảo quản nhằm hạn chế sự hư hỏng của sản phẩm và kéo dài thời gian sử dụng. Hiệu quả của Benzoic Acid đặc biệt rõ trong môi trường có tính acid, nơi hoạt chất có thể phát huy tốt khả năng kháng khuẩn và kháng nấm.
Ngoài đặc tính bảo quản, Benzoic Acid còn được sử dụng như một nguyên liệu trung gian quan trọng trong tổng hợp hóa học. Từ hợp chất này có thể tạo ra nhiều dẫn xuất và hợp chất hữu cơ khác phục vụ cho nhiều mục đích khác nhau. Bên cạnh đó, nhờ đặc tính kháng khuẩn nhẹ, Benzoic Acid cũng có thể được ứng dụng trong một số chế phẩm nhằm hỗ trợ kiểm soát sự phát triển của vi sinh vật.

Liều dùng & cách dùng
Benzoic Acid được sử dụng với nhiều mục đích khác nhau, tuy nhiên cách dùng thường phụ thuộc vào dạng chế phẩm và mục đích sử dụng cụ thể. Hoạt chất này có thể được dùng trực tiếp hoặc dưới dạng muối benzoat trong các sản phẩm nhằm phát huy tác dụng ức chế vi sinh vật và hỗ trợ bảo quản.
Trong các chế phẩm dùng ngoài da, Benzoic Acid thường được sử dụng ở nồng độ thấp trong dạng kem, thuốc mỡ hoặc dung dịch bôi. Khi sử dụng, người dùng cần làm sạch vùng da cần điều trị, sau đó thoa một lớp mỏng lên bề mặt da theo hướng dẫn của nhân viên y tế. Việc dùng đúng liều lượng và thời gian khuyến cáo giúp đạt hiệu quả tốt hơn và hạn chế nguy cơ kích ứng da.
Khi được dùng với vai trò chất bảo quản, Benzoic Acid hoặc các muối của nó sẽ được bổ sung với hàm lượng phù hợp theo quy định an toàn. Liều lượng sử dụng phải tuân theo tiêu chuẩn của cơ quan quản lý để đảm bảo hiệu quả bảo quản đồng thời tránh ảnh hưởng không mong muốn đến sức khỏe.

Ứng dụng
Trong công nghiệp thực phẩm
Benzoic Acid thường được sử dụng với vai trò chất bảo quản nhằm hạn chế sự phát triển của vi khuẩn, nấm men và nấm mốc. Hoạt chất này hoặc các muối của nó (như natri benzoat) được bổ sung với hàm lượng nhỏ vào sản phẩm, đặc biệt trong các thực phẩm có môi trường acid. Việc sử dụng phải tuân theo giới hạn cho phép của các cơ quan quản lý an toàn thực phẩm để đảm bảo hiệu quả bảo quản và an toàn cho người tiêu dùng.
Trong mỹ phẩm
Benzoic Acid được sử dụng như một thành phần giúp ổn định sản phẩm và hạn chế sự phát triển của vi sinh vật trong các công thức mỹ phẩm. Hoạt chất thường có mặt trong một số sản phẩm chăm sóc da và tóc với nồng độ phù hợp nhằm duy trì chất lượng sản phẩm trong suốt thời gian sử dụng. Nồng độ sử dụng được kiểm soát theo tiêu chuẩn an toàn của ngành mỹ phẩm.
Trong y học và dược phẩm
Trong lĩnh vực y học, Benzoic Acid có thể được sử dụng trong một số chế phẩm dùng ngoài da nhằm hỗ trợ kiểm soát vi sinh vật trên bề mặt da. Hoạt chất thường được bào chế dưới dạng kem, thuốc mỡ hoặc dung dịch bôi và có thể được kết hợp với các thành phần khác để tăng hiệu quả điều trị. Việc sử dụng cần tuân theo hướng dẫn của nhân viên y tế hoặc chỉ định của nhà sản xuất để đảm bảo an toàn.

Lưu ý
Các lưu ý khi sử dụng Benzoic Acid:
- Benzoic Acid thường được dùng để bào chế các thuốc điều trị dùng ngoài da. Khi sử dụng các chế phẩm này, người bệnh cần tuân thủ đúng hướng dẫn của bác sĩ hoặc khuyến cáo của nhà sản xuất về liều lượng và tần suất sử dụng. Trong đa số trường hợp, thuốc được bôi khoảng 2 lần mỗi ngày, tuy nhiên liều dùng có thể được điều chỉnh tùy theo tình trạng cụ thể.
- Thuốc chỉ nên sử dụng trên vùng da lành hoặc vùng da cần điều trị theo chỉ định. Người dùng không nên bôi thuốc lên vết thương hở, vùng da bị cháy nắng, da khô nứt hoặc đang bị kích ứng. Nếu thuốc vô tình tiếp xúc với các khu vực nhạy cảm như mắt, miệng hoặc mũi, cần rửa sạch ngay bằng nhiều nước để tránh kích ứng.
- Trước khi thoa thuốc, nên làm sạch vùng da cần điều trị, có thể rửa nhẹ bằng nước muối sinh lý rồi lau khô. Sau đó, bôi một lượng thuốc vừa đủ và xoa nhẹ để giúp hoạt chất thẩm thấu tốt hơn vào da. Vùng da đã bôi thuốc không nên băng kín, đồng thời cần giữ vệ sinh sạch sẽ để hạn chế nguy cơ nhiễm trùng.
- Các chế phẩm chứa Benzoic Acid dùng ngoài da không được sử dụng theo đường uống. Trong quá trình điều trị, người bệnh nên theo dõi phản ứng của cơ thể. Nếu triệu chứng không cải thiện sau khoảng 7 ngày sử dụng, hoặc xuất hiện dấu hiệu kích ứng hay tác dụng không mong muốn, cần ngừng thuốc và trao đổi với bác sĩ để được tư vấn và điều chỉnh phù hợp.
- Ngoài ra, thuốc không nên dùng cho những người có tiền sử dị ứng với Benzoic Acid hoặc các thành phần liên quan trong chế phẩm. Việc sử dụng đúng cách và đúng chỉ định sẽ giúp đảm bảo hiệu quả điều trị và hạn chế các rủi ro không mong muốn.
- Drugscom: https://www.drugs.com/inactive/benzoic-acid-22.html
- Drugbank: https://go.drugbank.com/drugs/DB03793
- benzoic acid: https://www.britannica.com/science/benzoic-acid
Các sản phẩm có thành phần Benzoic Acid
Gel bôi trơn Durex play classic (3 gói x 5ml)
Nước súc miệng Listerine Green Tea bảo vệ răng miệng suốt 24 giờ (250ml)
Nước súc miệng chăm sóc toàn diện không cay Listerine Total Care Zero Alcohol Mouthwash 250ml
Nước súc miệng chăm sóc toàn diện không cay Listerine Total Care Zero Alcohol Mouthwash 750ml
Nước súc miệng giảm mảng bám Listerine Tartar Protection 250ml
Sữa chống nắng Anessa Perfect UV Sunscreen Mild Milk SPF 50+ PA++++ dịu nhẹ cho da nhạy cảm và trẻ em (60ml)
:format(webp)/Option_1_2_2d9677e5fd.png)
:format(webp)/Option_1_1_2a84e0cd00.png)
